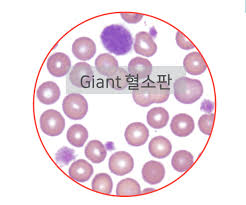

반응형
혈소판은 혈액 응고를 담당하는 중요한 세포 성분으로, 수치가 낮아지면 출혈 위험 증가는 물론, 특정 질환의 신호일 수 있습니다. 이번 글에서는 혈소판 수치 저하의 원인, 증상, 진단, 치료법, 일상 관리까지 2,500자 이상으로 자세히 안내드립니다.
1. 혈소판이란?



- 혈소판(Platelet, PLT)은 골수에서 생성되는 세포 파편으로, 출혈이 발생했을 때 혈관벽에 모여 **혈전을 형성**하며 지혈 작용을 수행합니다.
- 정상 혈소판 수치는 150,000~450,000/μL이며, 이보다 낮으면 혈소판 감소증(Thrombocytopenia)으로 간주됩니다.
2. 혈소판 수치가 낮아지는 주요 원인



- 골수 기능 저하: 백혈병, 골수섬유증, 항암치료, 방사선 치료 등으로 혈소판 생성 자체가 감소합니다.
- 자가면역 질환: 면역성 혈소판감소증(ITP)처럼 면역계가 혈소판을 오인하여 파괴하는 질환.
- 간 질환: 간경변 등에서 비장 비대가 발생하여 혈소판이 많이 파괴됩니다.
- 약물: 항생제, 항경련제, 항암제, 항응고제 등 일부 약물이 혈소판 감소를 유발할 수 있습니다.
- 감염: B형/C형 간염, HIV, 헬리코박터균, 뎅기열 등 바이러스 감염이 원인일 수 있습니다.
3. 혈소판 수치 저하의 대표 증상



- 피부에 멍이 쉽게 생김
- 자주 코피가 남 혹은 양치 시 잇몸 출혈
- 월경량 증가 또는 생리통이 심해짐
- 소화기/비뇨기 출혈: 혈뇨, 혈변 등
- 심한 경우: 뇌출혈, 위장관 출혈 같은 생명 위협적 상태 발생
4. 혈소판 수치 단계별 위험도
| 수치 (/μL) | 위험도 | 관리 방법 |
|---|---|---|
| 100,000~150,000 | 경미한 감소 | 원인 찾기, 정기 모니터링 |
| 50,000~100,000 | 주의 필요 | 출혈 유발 활동 제한, 진단 필요 |
| 20,000~50,000 | 중등도 위험 | 자연출혈 가능성 증가, 의료 개입 필요 |
| 10,000 미만 | 고위험 | 입원 및 수혈 등 긴급 치료 필요 |
5. 진단 방법



- CBC(전혈구 검사): 혈소판 수치 측정의 기본검사.
- 말초혈액도말 검사: 혈소판의 형태 및 분포 상태 확인.
- 골수 검사: 골수 기능 평가를 통한 백혈병, 골수이형성증 등 확인.
- 자가면역 항체 검사, 간기능 검사, 바이러스 혈청 검사 등 원인 감별 위한 정밀검사 병행.
6. 치료 방법

- 원인 질환 치료: 간질환, 감염, 자가면역 질환 등에 따라 치료 계획 다름.
- 면역억제제 사용: ITP와 같은 경우 스테로이드(프레드니솔론), 면역글로불린(IVIG) 사용.
- 혈소판 수혈: 수치가 10,000 미만이거나 대수술 전, 출혈 동반 시 필요.
- 신약 치료: 혈소판 생성 자극제(TPO 수용체 작용제) 사용 가능.
7. 일상 관리법과 주의사항



- 과격한 운동 자제: 부딪힘, 외상으로 인한 출혈 주의
- 이발, 면도 시 칼 사용 주의
- 치실, 딱딱한 칫솔 대신 부드러운 칫솔 사용
- 술, 해열진통제(NSAIDs) 등 금지: 혈소판 기능 저해 요인
- 건강보조식품·약물 복용 전 전문의 상담
8. 병원에 가야 하는 응급 증상



- 갑작스러운 심한 멍, 코피, 잇몸 출혈
- 두통 동반한 의식 저하 또는 구토 → 뇌출혈 의심
- 복통·혈변·혈뇨 지속 → 장기 출혈 가능성
📌 요약 정리
- 혈소판은 혈액 응고에 필수적인 요소이며, 수치가 낮아지면 출혈 위험이 커집니다.
- 감염, 자가면역, 약물, 골수 질환 등 다양한 원인이 존재합니다.
- 진단은 CBC, 혈액도말, 골수검사 등을 통해 이루어지며, 원인에 따라 치료 방식이 다릅니다.
- 출혈 예방을 위한 생활습관 개선과 정기적인 의료관리, 응급 증상 시 병원 진료가 매우 중요합니다.
반응형